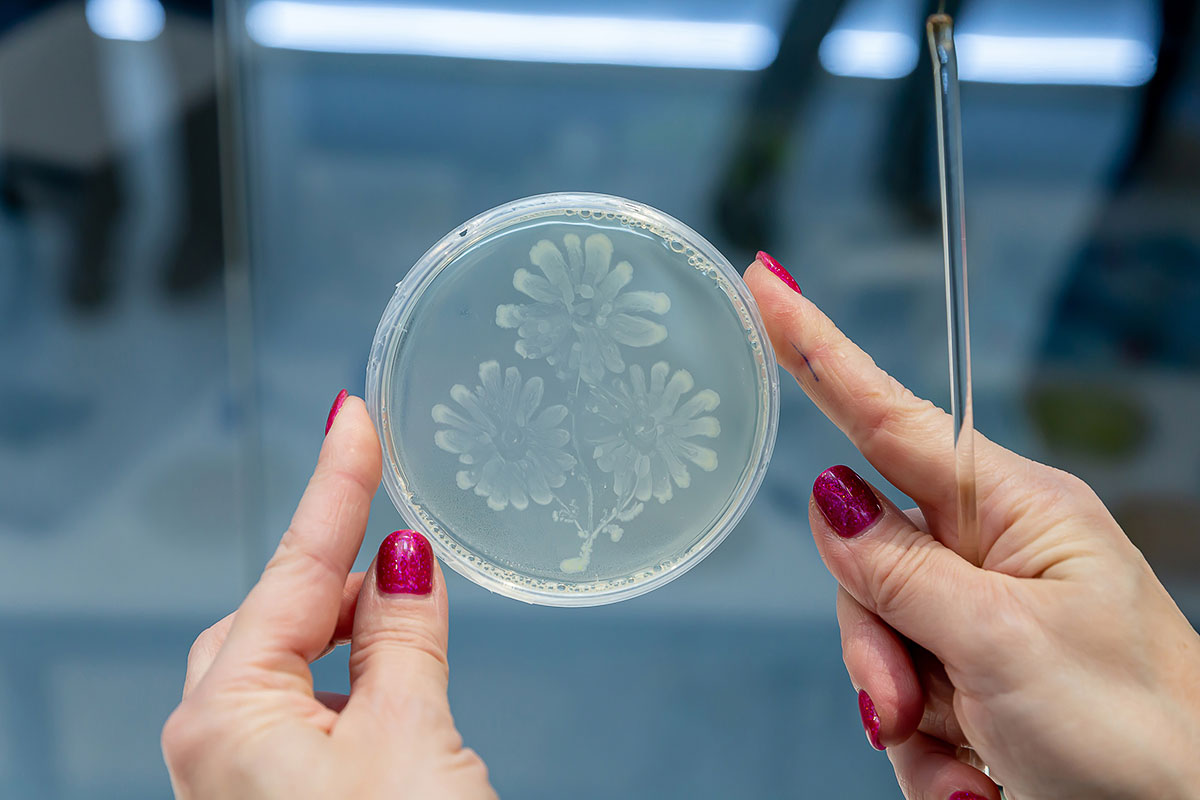

Европолитест
Злоба геншин кому
Программы бесплатные для водителей
Время старого бога книга
Когда сажать ремонтантную малину осенью или весной
The crow саундтреки
Как шнуровать самбы
Симс 4 трубы
Сколько финалов в лиге чемпионов
Каприччио гаврилин фортепиано
Балеты современной хореографии
Ну подавись
Песня my baby тик ток
Pentax k 3 iii
Европолитест 135 фотографий